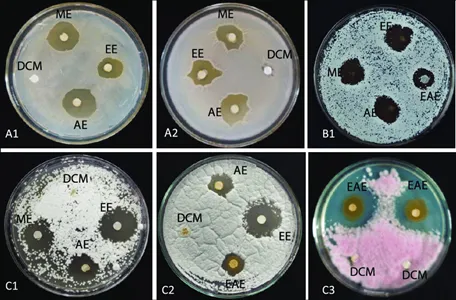
Antimicrobial activity Antimicrobial activity

CAS 477 47 4 IGF 1R
Picropodophyllotoxin dufter efnasamband með Chemical Abstracts Service (CAS) skráningarnúmerið 477 47 4 og flókinn insúlínlíkan vaxtarþátt 1 viðtaka (IGF-1R). Viðtakaprótein sem kallast IGF-1R er nauðsynlegt fyrir lifun frumna, vöxt og skiptingu. Vegna þess að þeir eiga þátt í að hvetja til þróunar dauðra frumna og ónæmis gegn tilteknum meðferðum, eru sjúkir frumur í brennidepli í rannsóknum þess.
Það fer líka eftir PPT og er lignan, efnafræðilega séð. Það hefur vakið áhuga fyrir hugsanlegri læknisfræðilegri notkun þess. Fjölmargar tegundir af Podophyllum sinensis, Aniseliana og Podophyllum eru meðal plantna sem innihalda það. Vegna möguleika þeirra sem lyf hafa podophyllotoxín vakið mikla athygli í vísindarannsóknum. Rannsóknir benda til þess að með því að efla frumudauða og draga úr myndun sjúkra frumna gæti það haft eiginleika gegn alvarlegum sjúkdómum. Hvítblæði, brjóst-, lungna- og ristilvandamál eru nokkrir frumusjúkdómar sem rannsakaðir eru með þessari aðferð. Vegna hugsanlegra eiginleika þeirra hafa podophyllotoxín vakið athygli í lækningarannsóknum. Verið er að rannsaka væntanlegar umsóknir þess, verið er að laga byggingargalla þess og reynt er að þróa hliðstæður sem eru eiturefnalausari og öflugri en jafnframt skilvirkari. Xi'an Sonwu getur veitt þér hreint píkrópódófýlótoxín; ef þú hefur áhuga á lignan vörum geturðu haft samband við Xi'an Sonwu hvenær sem er.

Greiningarvottorð
|
Atriði |
Forskrift |
Niðurstaða |
|
Greining |
Meira en eða jafnt og 98 prósent |
98,69 prósent |
|
Einkenni |
||
|
Útlit |
Hvítt duft |
Samræmist |
|
Lykt |
Einkennandi |
Samræmist |
|
Bragð |
Einkennandi |
Samræmist |
|
Tap á þurrkun |
Minna en eða jafnt og 5.0 prósent |
0.32 prósent |
|
Innihald ösku |
Minna en eða jafnt og 1,0 prósent |
0.19 prósent |
|
Magnþéttleiki |
1,4±0,1 g/cm3 |
1,4±0,1 g/cm3 |
|
Þungmálmar |
||
|
Heildarþungmálmar |
Minna en eða jafnt og 10ppm |
Samræmist |
|
Arsenik |
Minna en eða jafnt og 2 ppm |
Samræmist |
|
Blý |
Minna en eða jafnt og 2 ppm |
Samræmist |
|
Örverufræðileg próf |
||
|
Heildarfjöldi plötum |
Minna en eða jafnt og 1000cfu/g |
Samræmist |
|
Samtals ger og mygla |
Minna en eða jafnt og 100cfu/g |
Samræmist |
|
E.Coli |
Neikvætt |
Neikvætt |
|
Salmonella |
Neikvætt |
Neikvætt |
|
Staphylococcus |
Neikvætt |
Neikvætt |
CAS 477 47 4 duft til sölu
Með meira en áratug af sérfræðiþekkingu á markaðnum og áherslu á framleiðslu og dreifingu hráefna, hefur Xi'an Sonwu Biotech Co. Ltd. , og Eyjaálfu. Xi'an Sonwu setur vörugæði í fyrsta sæti og leitast við að veita hverjum viðskiptavinum hágæða þjónustu til að mæta þörfum þeirra að fullu.
Fyrir Xi'an Sonwu er það aðal áhyggjuefni að framleiða hágæða vörur. Þessi vígsla til afburða er áberandi í öllum hlutum fyrirtækisins, þar á meðal efnisvali, framleiðsluferlum, sýnishornsprófum og fagmennsku starfsfólks. Til að draga úr útgjöldum án þess að fórna gæðum og tryggja að viðskiptavinir fái vörur af framúrskarandi verðmætum, stjórnar Xi'an Sonwu vandlega öllum þáttum.
Xi'an Sonwu er stoltur af jákvæðum viðbrögðum sem það hefur fengið frá viðskiptavinum, sem hafa stöðugt viðurkennt gæði vörunnar. Til að sanna enn frekar traust vöru mun Xi'an Sonwu veita þér sýnishorn til að prófa.
|
CAS 477 47 4 eyðublað |
Dæmi magn |
Lágmarks magn |
|
Púður |
1g |
1g |
Góð athugasemd viðskiptavina

Hver er verkunarháttur Podophyllum
Picropodophyllotoxin duftVerkunarháttur og markmið þess eru enn í rannsókn og takmarkaðar upplýsingar eru til um sérstök sameindamarkmið þess. En samkvæmt nýlegum rannsóknum er talið að það hafi samskipti við nokkur frumumarkmið, sem gæti verið þáttur í hugsanlegum lækningalegum áhrifum þess.
Hömlun á DNA Topoisomerase II: Það hefur samskipti við DNA Topoisomerase II, mikilvægt ensím í DNA eftirmyndun og viðgerð, og kemur í veg fyrir að það virki. Með því að hindra þetta ensím truflar það eðlilega virkni tópóísómerasa II við stjórnun DNA uppbyggingu og heilleika.
DNA skemmdir og frumuhringstöðvun: Hömlun tópóísómerasa II með því leiðir til stöðugra þrískipta fléttna milli lyfsins, tópóísómerasa II og DNA. DNA skemmdir af völdum þessara fléttna fela í sér brot á DNA strengi og DNA-prótein krosstengingar. DNA-skemmdir safnast upp og veldur því að frumuskiptin stöðvast og stöðva frumuhringinn.
Truflun á myndun örpípla: Mikilvægu frumuþættirnir þekktir sem örpíplar gegna hlutverki í mörgum frumustarfsemi, þar með talið frumuskiptingu. Þegar örpíplar bila við frumuskiptingu valda podophyllotoxín eyðileggingu með aðskilnaði litninga. Með því að hamla þessu ferli koma podophyllotoxín í veg fyrir frumuskiptingu og útbreiðslu, sem hindrar að lokum vöxt sjúkra frumna.
Auk áhrifa þess á örpípla hefur það mótað ýmsar boðleiðir sem taka þátt í lifun frumna og frumudauða (forritaður frumudauði). Þessum ferlum er stjórnað, meðal annarra próteina, af Bcl-2, kaspasum og p53. Það getur kallað fram frumudauða í veikum frumum og ógnað lifun með því að trufla þessa ferla.
Andoxunareiginleikar þess hafa verið uppgötvaðir, sem geta hjálpað til við að útskýra hugsanleg áhrif þess. Það getur dregið úr frumuskemmdum og aukið almenna heilsu þeirra með því að lækka oxunarálag.

CAS 477 47 4 Áhrif IGF 1R
1. Bólgueyðandi áhrif
Bólga er náttúruleg viðbrögð líkamans við meiðslum. En langvarandi bólga hefur verið tengd við upphaf og framvindu sjúkdóma eins og sjúkar frumur, sykursýki og hjarta- og æðasjúkdóma. Samkvæmt bráðabirgðarannsóknum getur það haft bólgueyðandi kosti með því að hindra framleiðslu bólgueyðandi sameinda.
2. Andoxunareiginleikar
Þegar getu líkamans til að afeitra hvarfgjörn súrefnistegundir (ROS) og sköpun þeirra er í ójafnvægi, veldur oxunarálagi. Fjölmargir sjúkdómar, eins og sjúkar frumur, taugasjúkdómar og hjarta- og æðasjúkdómar, verða fyrir áhrifum af oxunarálagi. Andoxunareiginleikar hafa verið uppgötvaðir í því, sem geta hjálpað til við að draga úr oxunarálagi og verja frumur fyrir ROS-tengdum frumuskemmdum.
3. Örverueyðandi virkni
Það getur haft bakteríudrepandi eiginleika, samkvæmt nokkrum rannsóknum. Það hefur sýnt virkni gegn ýmsum sjúkdómum, þar á meðal sveppum og bakteríum. Það getur komið í veg fyrir vöxt þessara baktería með því að hindra mikilvæga líffræðilega aðgerðir eins og DNA afritun og frumuskiptingu.
4. Taugaverndandi áhrif
Bæði Alzheimerssjúkdómur og Parkinsonsveiki eru taugahrörnunarsjúkdómar sem smám saman eyðileggja taugafrumur í heila. Það hefur sýnt fram á efnilegar niðurstöður í fyrstu rannsóknum sem hugsanlegt taugavarnarlyf. Það getur dregið úr bólgusjúkdómum í heila, verndað taugafrumur gegn oxunarskemmdum og aukið lífvænleika frumna.
5. Veirueyðandi áhrif
Það gæti haft veirueyðandi getu, samkvæmt sumum rannsóknum. Fjölmargar vírusar, þar á meðal öndunarfæraveirur og herpes simplex, eru hindraðir af því. Enn er verið að rannsaka sérstakar aðferðir sem það beitir veirueyðandi áhrifum sínum.
CAS 477 47 4 Aukaverkanir til langs tíma
Meltingarfæratruflanir: Notkun lífrænna efna með frumudrepandi áhrif, eins og píkrópódófýlótoxín, getur stundum valdið meltingarfæravandamálum eins og ógleði, uppköstum eða niðurgangi. Ef þessar aukaverkanir koma fram er nauðsynlegt að leita til læknis.
Ofnæmisviðbrögð: Sumir einstaklingar geta verið með ofnæmi fyrir því, eins og á við um öll önnur efni. Það verður kláði, útbrot, bólga eða öndunarerfiðleikar. Ef þú finnur fyrir einhverjum þessara einkenna eftir notkun er mikilvægt að leita læknishjálpar tafarlaust.
Milliverkanir við lyf eða önnur efni: Það getur haft samskipti við ákveðin lyf eða efni. Segjum sem svo að þú sért að taka einhver lyf eða ert með undirliggjandi heilsufar. Í því tilviki er nauðsynlegt að hafa samráð við heilbrigðisstarfsmann eða læknisfræðing áður en það er notað til að forðast hugsanlegar milliverkanir.
Verksmiðja
1. Xi'an Sonwu Biotech Co., Ltd hefur verksmiðju til að framleiða, framleiða og geyma vörurnar, þannig að það hefur fullnægjandi lager. Xi'an Sonwu er með vel skipaða, hreina og snyrtilega framleiðsludeild. Undir Xi'an Sonwu geta vísindamenn stöðugt þróað hágæða nýjar vörur.
2. Xi'an Sonwu hefur strangar kröfur um úthlutun starfsmanna frá framleiðslu og prófunum til sölu. Til að tryggja að hverri vöru sé fylgt er strangur gagnastuðningur og þjónusta eftir sölu veitt.

Vottorð

Pakki

Vörustjórnun

Fyrir utan að tryggja vöruna, er mikilvægast að viðskiptavinir geti fengið vörurnar vel. Svo, Xi'an Sonwu útvegar alls kyns hraðboða í samræmi við mismunandi þarfir.

Algengar spurningar
Það skal tekið fram að það er líka til lignan vara sem kallast podophyllotoxin og picropodophyllotoxin, og það eru tvö mismunandi efnasambönd; podophyllotoxin er náttúrulegt efnasamband sem venjulega er unnið úr plöntum eins og Mayapple (Podophyllum peltatum). En picropodophyllotoxin fannst í Podophyllum hexandrum plöntunni.
Ef þú vilt vita framleiðanda picropodophyllotoxin þykkni dufts geturðu haft samband við Xi'an Sonwu. Smelltu á tölvupóstinn og þá færðu hágæðapíkrópódófýlótoxín duft.
Netfang:sales@sonwu.com
maq per Qat: picropodophyllotoxin duft, Kína, birgja, framleiðendur, verksmiðju, heildsölu, kaupa, verð, magn, hreint, hrátt, framboð, til sölu













